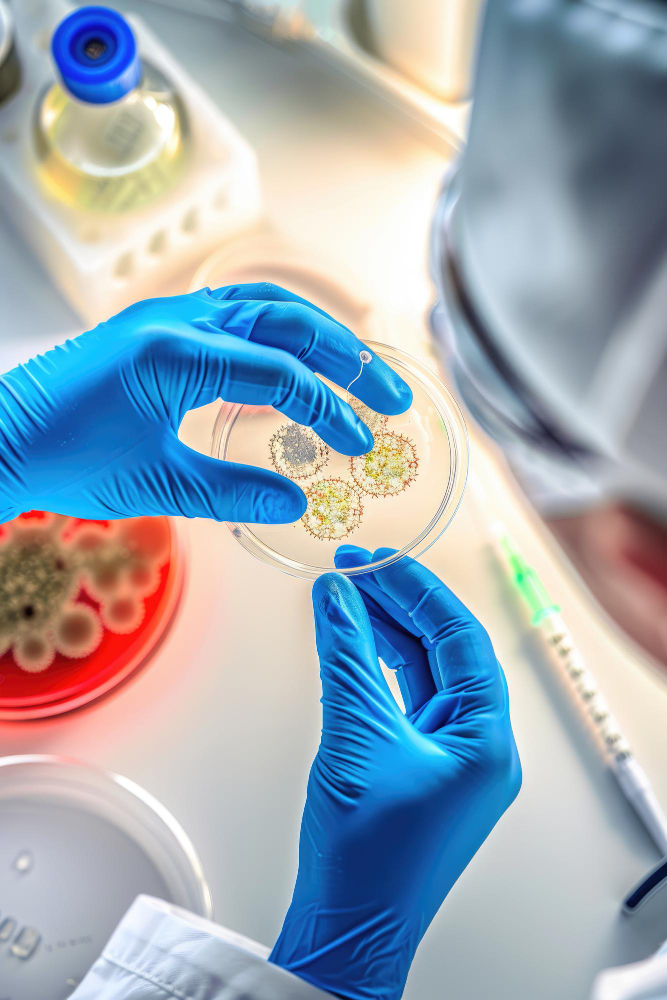

Çfarë eshte OncoNext ?
Predispozicion i trashëguar ndaj kancerit
Monitorimi i terapisë së kancerit
Profilizimi i tumorit
OncoNext…si zhvillohen tumoret?
Gjendje normale: Bilanci midis rritjes së qelizave dhe apoptozës. Qelizat që dëmtohen ose nuk nevojiten më vdesin dhe qelizat e reja krijohen për të zëvendësuar ato më të vjetrat ose për të kryer funksione të reja. Nëse ekuilibri i rritjes dhe vdekjes së qelizave është i shqetësuar, mund të formohet një tumor. Rritje jonormale e indeve të trupit Rritja e qelizave Apoptoza
OncoNext RISK
Onconext RISK…predispozicion tumoral Testimi gjenetik ndihmon në vlerësimin e mundësisë së zhvillimit të kancerit gjatë gjithë jetës.
Onconext Risk mund të ndihmoj:
- Për të parashikuar rrezikun e një sëmundjeje të caktuar
- Për të gjetur nëse dikush ka mutacione gjenesh që mund të kalojnë një rrezik në rritje të kancerit tek fëmijët
- Të japë informacion për të udhëhequr planet e kujdesit shëndetësor
OncoNext Likuid
Është një test diagnostik i cili zbulon praninë e mutacioneve somatike duke analizuar ADN-në qarkulluese të tumorit (ctDNA) në gjakun periferik.
Biopsia e ngurtë vs Biopsia likuide
Biopsia e ngurtë – Ofron informacion citologjik dhe histologjik thelbësor për diagnozën Invazive, e rrezikshme, e dhimbshme; Përfaqësues vetëm i pikës së kampionimit; I kufizuar në tumor primar.
Biopsia likuide – Ofron profilizimin gjenetik të tumorit të dobishëm për terapinë e synuar dhe për monitorimin e progresionit të tumorit; Jo invazive, e lehtë, e përsëritshme.
